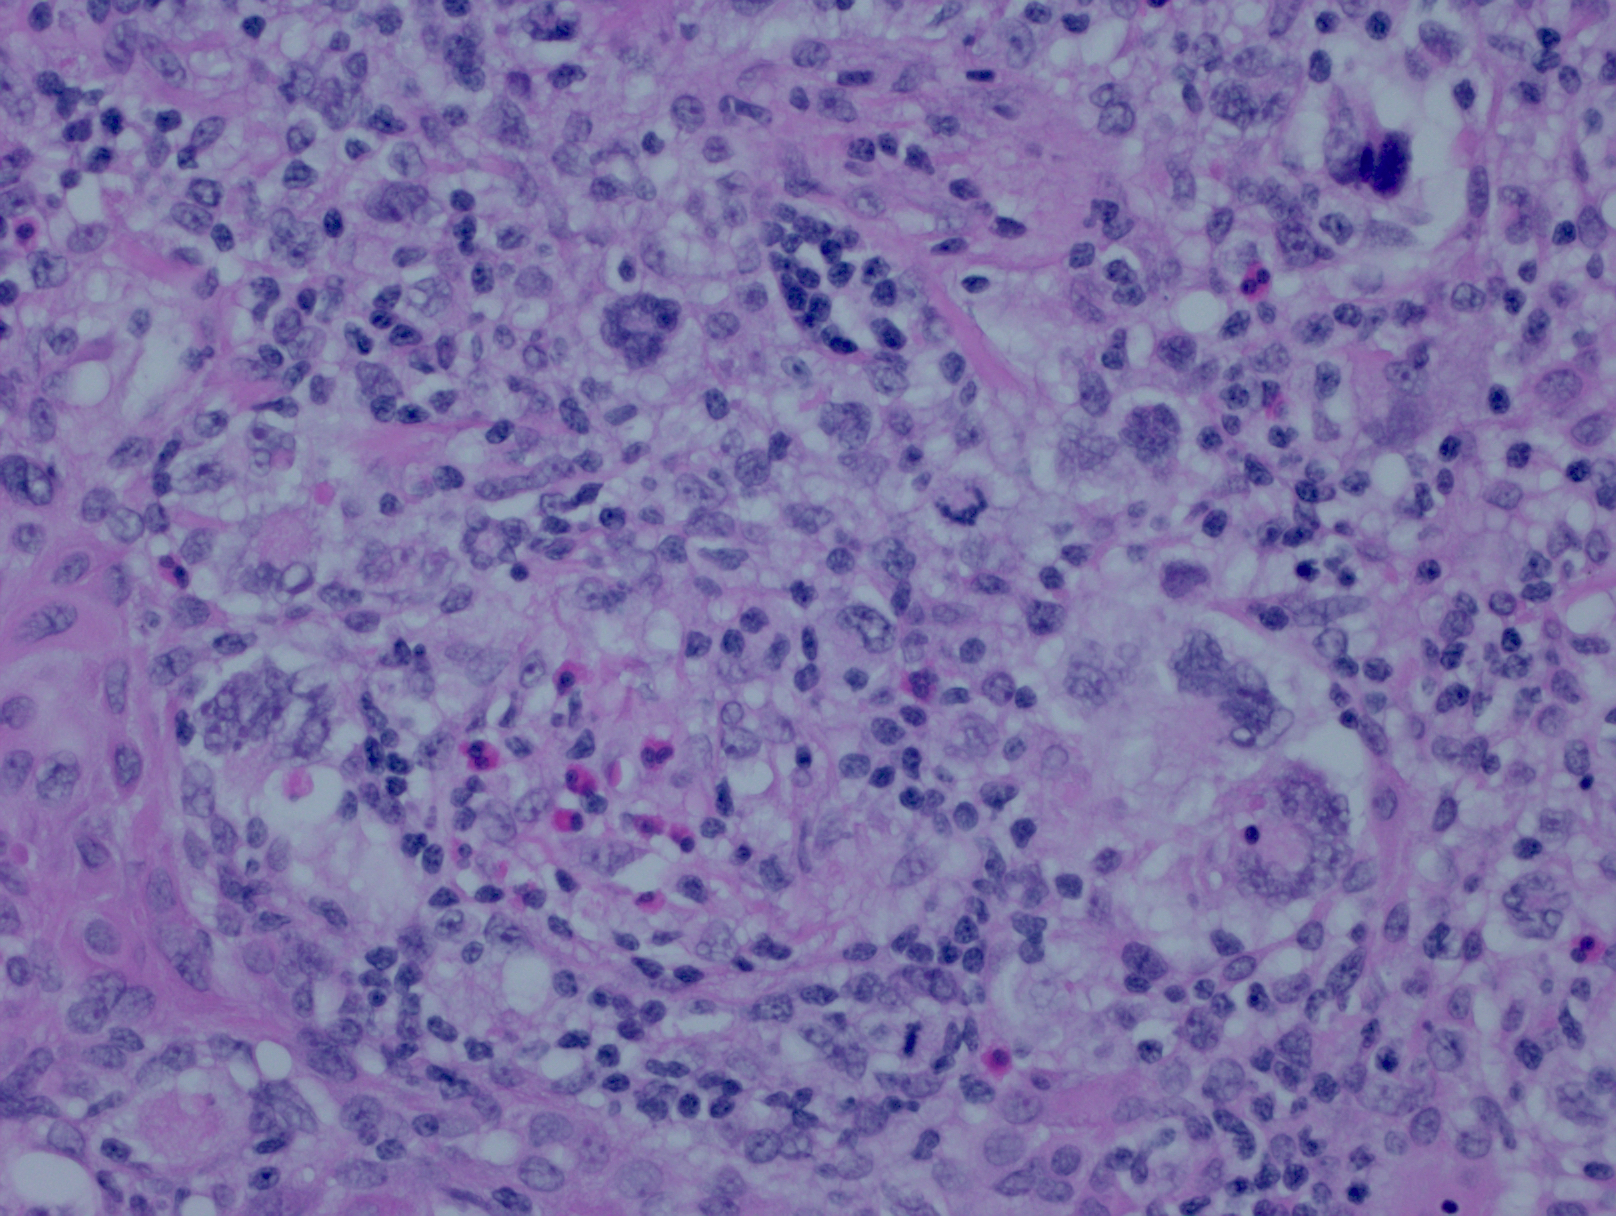
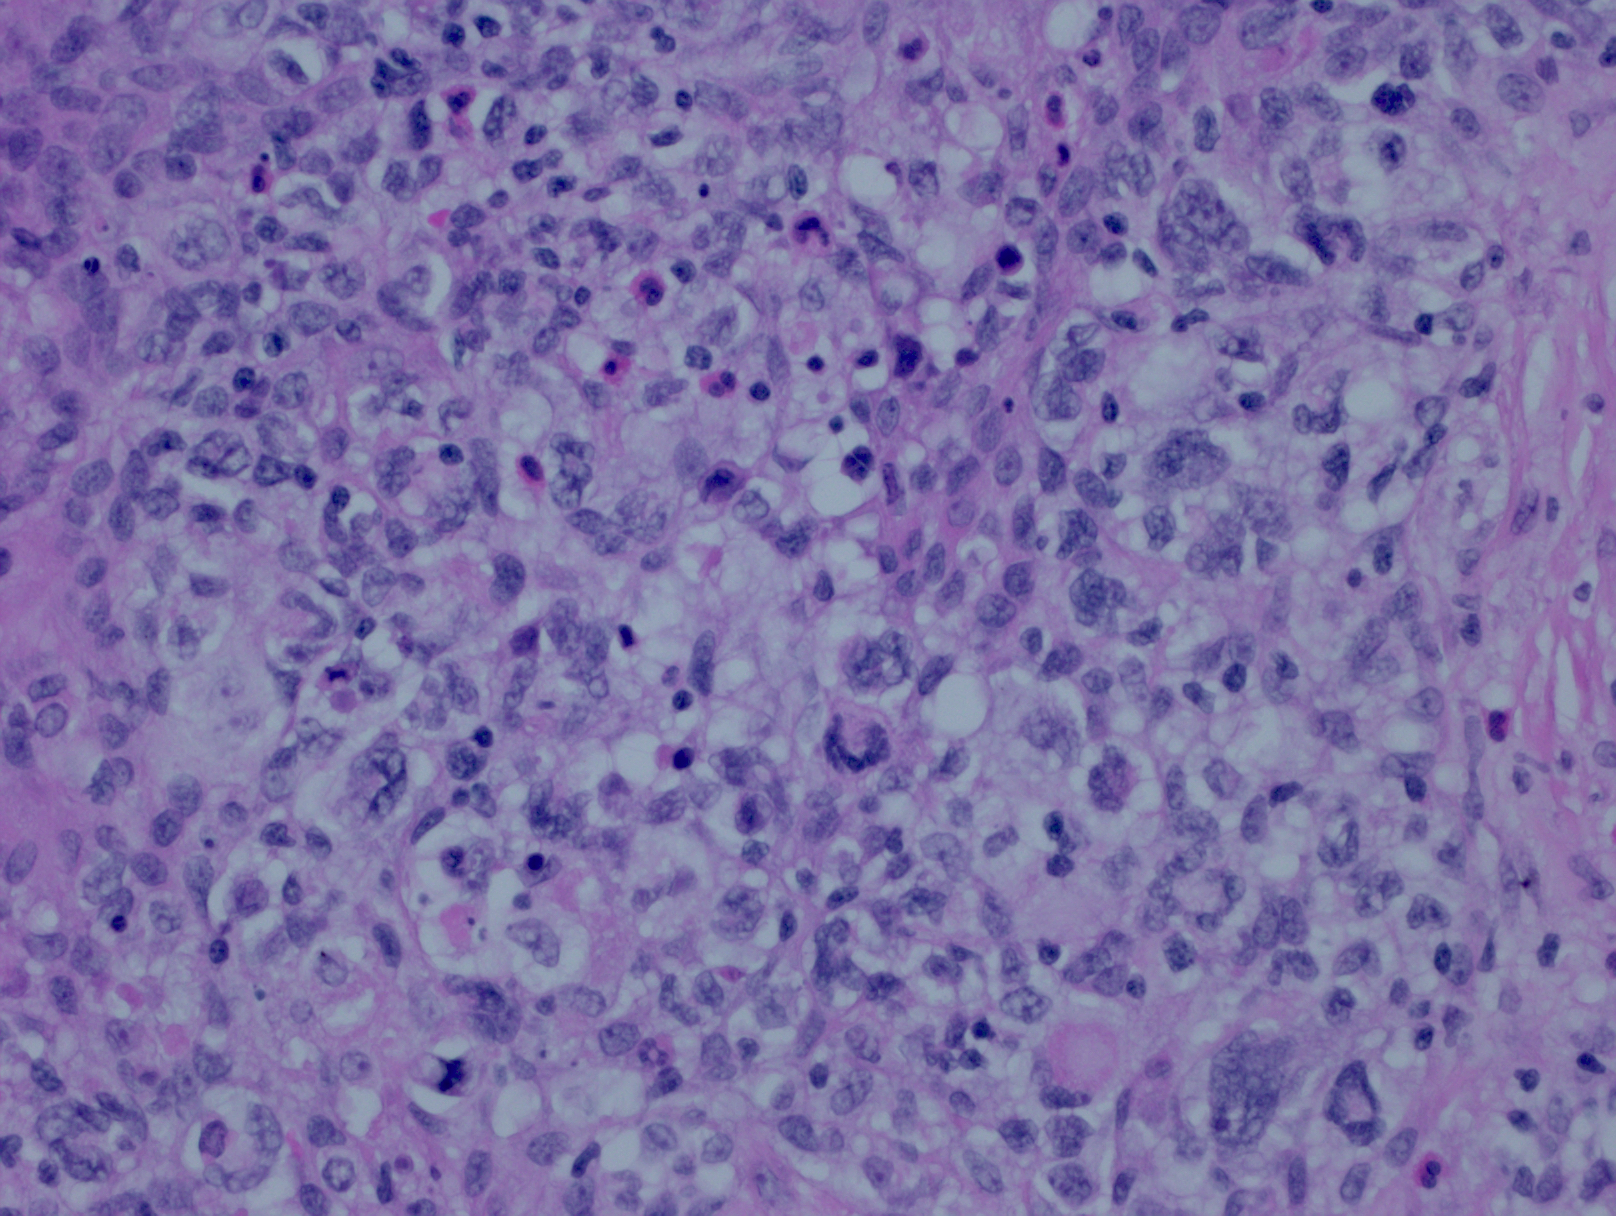
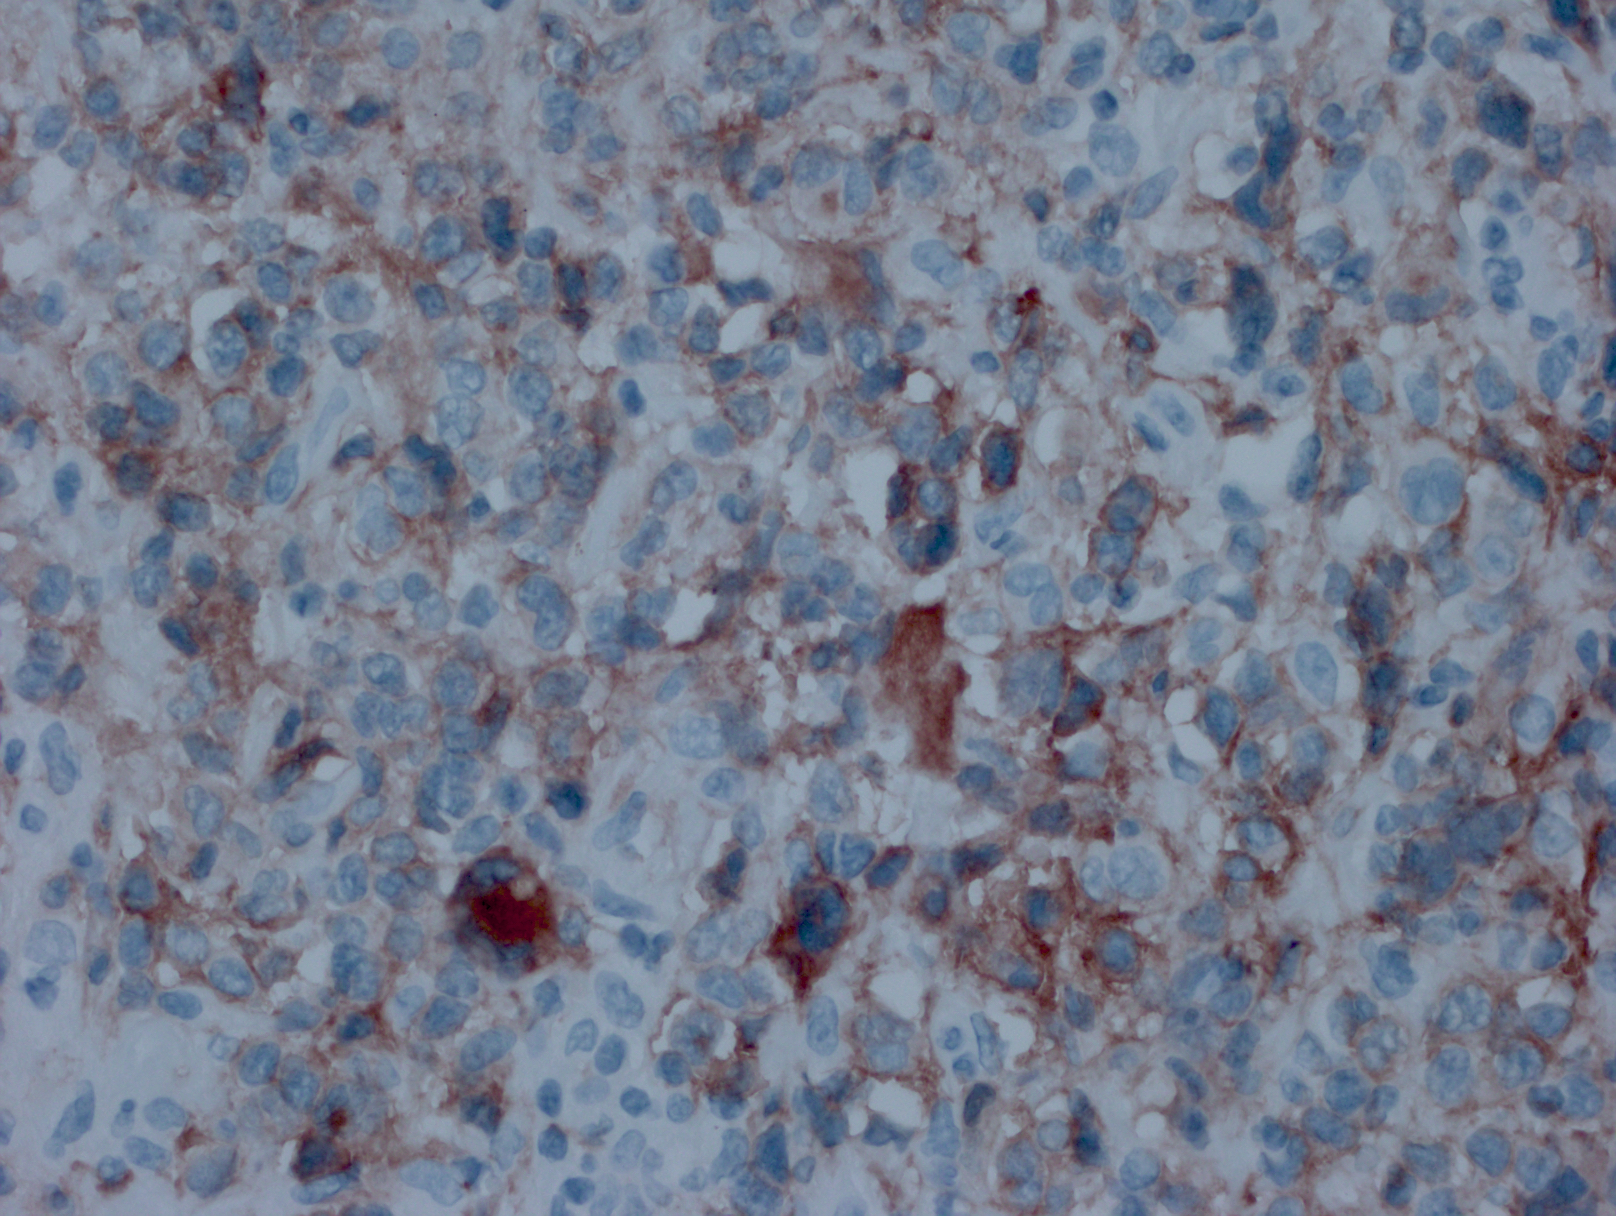

特征介于弥漫大 B 细胞淋巴瘤和经典型霍奇金淋巴瘤之间的未分类 B 细胞淋巴瘤
B-cell lymphoma, unclassifiable, with features intermediate between diffuse large B-cell lymphoma and classical Hodgkin lymphoma (DLBC-U)
概述:
这是一类 B 细胞淋巴瘤,但在临床、形态和/或免疫表型方面表现为经典霍奇金淋巴瘤(CHL)和弥漫性大 B 细胞淋巴瘤(DLBCL)的重叠特征。多见于胸腔纵隔,也有少数病例累及外周淋巴结。可简称前者为纵隔灰区淋巴瘤,后者为灰区淋巴瘤。
发病部位: 多见于胸腔纵隔,也有少数病例类及外周淋巴结。
诊断要点:
主要见于 20-40 岁,男性较多。表现为前纵隔大肿块并侵润临近器官(甚至锁骨上淋巴结),可引起的压迫症状(上腔静脉综合征或呼吸困难)。较少累及外周或腹腔淋巴结。可括散至肺、肝、脾及骨髓。
肿瘤由多形性大细胞组成并伴一定程度纤维化。可成片状生长,类似原发纵隔大 B 细胞淋巴瘤或弥漫大 B 细胞淋巴瘤;但也可散在侵润,类似经典霍奇金淋巴瘤。这两种生方式可见于同一病例的不同区域。
细胞形态多样,中心母细胞、免疫母细胞和 HRS 细胞包括腔隙性样细胞。有少量炎性背景细胞如散在的嗜酸细胞、组织细胞和小淋巴细胞。
免疫表型:肿瘤细胞表达“混合”抗原,符合弥漫大 B 细胞淋巴瘤和经典霍奇金淋巴瘤的双重特征。CD45+,CD30+,多数 CD15 阳性,CD20 和 CD79a 通常阳性,PAX5. Oct2. 和 BOB1 一般也阳性。Bcl-6+/-, CD10-。 EBER 一般阴性(但也有极少阳性病例报道)。
形态学似弥漫大 B 淋巴瘤,但免疫学符合经典霍奇金淋巴瘤;形态学提示经典霍奇金淋巴瘤,但免疫表型却更倾向 B 细胞瘤。
多数病例有单克隆 IgH 基因重排。

免疫组织化学染色:
肿瘤细胞表达“混合”抗原,符合弥漫大 B 细胞淋巴瘤和经典霍奇金病的双重特征。CD45+,CD30+,多数 CD15 阳性,CD20 和 CD79a 通常阳性,PAX5. Oct2. 和 BOB1 一般也阳性。Bcl-6+/-,CD10-。EBER 一般阴性。
鉴别诊断:
- 原发性纵隔(胸腺)大 B 细胞淋巴瘤 (PMLBCL):通常见于年轻女性,前上纵隔快速生长肿块。肿瘤细胞弥漫增生,胞浆常淡然或透明。背景纤维化使瘤细胞分割区块化。表达泛 B 细胞抗原如 CD20. CD79a、PAX5,LCA+。 大多数 CD30 阳性,但为局灶性或较弱,且 CD15 阴性。多数 CD23+。
- 弥漫性大 B 细胞淋巴瘤 (DLBCL, NOS):发病年龄不定,多为中老年,有胸腔外淋巴节肿大。肿瘤呈现弥漫生长,细胞形态类似中心母细胞或免疫母细胞。泛 B 细胞抗原和 LCA 阳性,CD10 和 Bcl-6 常阳性,CD30 可以弱阳性或局灶阳性,CD15 阴性。
- 结节硬化型经典霍奇金淋巴瘤 (NSCHL):多为年轻患者,纵隔肿块。肿瘤呈现纤维化结节生长模式,由致密宽厚胶原带分割肿瘤实质而成。散在典型的 HRS 细胞(少数病例融合成合胞体)和大量的炎性背景细胞。免疫表型为典型的 CHL:CD30+、CD15+、PAX5+(弱)、CD45-。CD20-/+和 CD79a-/+,弱或不均匀表达。部分病例 EBER+。
- 间变性大细胞淋巴瘤 (ALCL):青少年(ALK+)或中老年(ALK-)发病。大型肿瘤细胞弥漫增生,可发现“标志性细胞”(偏心马蹄形或肾形核)。CD30 均匀强阳性(胞膜和 Golgi 区染色)。T 细胞相关抗原阳性(如 CD4),EMA 和细胞毒标记常阳性。B 细胞抗原阴性。
预后:
预后较经典霍奇金淋巴瘤和原发纵隔大 B 细胞淋巴瘤差。
